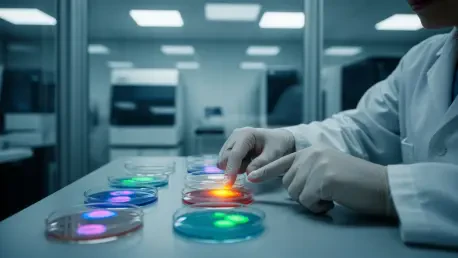

The human body is not a static reflection of the genetic code inherited at birth but rather a living laboratory of constant “micro-evolution” where cells compete, adapt, and mutate. This internal genetic mosaicism means that every individual is a collection of genetically distinct cell lineages, each carrying unique somatic mutations acquired throughout a lifetime. While science traditionally viewed these post-conception changes through the narrow lens of oncology, a profound shift is occurring. Researchers are now decoding how these mutations drive non-malignant diseases and, more importantly, how they occasionally grant cells an extraordinary resilience that can be harnessed for new therapies.
Somatic genomics is rapidly moving from the periphery to the center of modern medicine by redefining the concept of “normal” tissue. Traditionally, germline genetics—the study of inherited traits—dominated the search for drug targets. However, the realization that somatic mutations are ubiquitous even in healthy organs has opened a new frontier. By understanding how certain cells outcompete their neighbors through specific genetic advantages, scientists are uncovering natural mechanisms of cellular defense. This evolution-centric perspective is shifting the paradigm of drug discovery toward a model that mimics the body’s own successful adaptations.
This analysis explores the rising trajectory of somatic research and its practical utility in identifying novel therapeutic targets. It examines the industry shifts toward a Darwinian understanding of tissue health and details the emerging frameworks that prioritize somatic profiling. As precision medicine matures, the focus is expanding from fixing what is “broken” at birth to amplifying the “protective” mutations that the body develops during its own survival journey.
The Rising Trajectory of Somatic Genomic Research
Mapping the Expansion of the Somatic Landscape
The landscape of genomic data has expanded exponentially as sequencing technologies have become sensitive enough to detect low-frequency variants within a sea of healthy cells. Historically, these minor genetic deviations were dismissed as “noise” or technical artifacts. Today, high-depth sequencing reveals that “normal” tissues are actually vibrant mosaics of competing clones. This data explosion has fundamentally altered the scientific understanding of aging and tissue maintenance, showing that the genetic makeup of an organ at age sixty is vastly different from its state at age twenty.
As adoption trends accelerate, the focus of large-scale genomic projects has moved beyond the “Cancer Genome” into the realm of broader biomedical research. There is a visible surge in literature linking somatic mosaicism to various age-related and idiopathic conditions. This growth in data suggests that many diseases previously categorized as “unexplained” may actually be the result of specific somatic clones gaining a foothold in vital organs, such as the heart, liver, or brain.
From Bench to Bedside: Real-World Applications
Practical applications of somatic genomics are already appearing in clinical settings, particularly in treating conditions that were once considered intractable. For instance, focal epilepsies and complex vascular malformations are often caused by somatic mutations in the PI3K/AKT/mTOR signaling pathways. Because these mutations are only present in a small subset of cells, they remained invisible to traditional blood tests. Identifying these localized genetic drivers has allowed clinicians to repurpose oncology drugs that target these specific pathways, providing relief to patients who do not respond to standard treatments.
Beyond treating malfunctions, somatic genomics is uncovering “protective” mutations that serve as blueprints for the next generation of therapeutics. In the liver and intestinal tract, certain mutations in genes like ARID1A or those involved in IL-17 signaling appear to make cells more resilient to inflammation and toxins. By studying these “super-cells” that survive in harsh, diseased environments, pharmaceutical researchers are developing small molecules and gene therapies that mimic these natural survival strategies, effectively teaching healthy cells how to become more resilient.
Industry Insights: Deciphering the Selective Landscape
The Darwinian Selection Framework: Cellular Fitness Versus Health
Expert perspectives in the pharmaceutical industry are increasingly adopting a Darwinian framework to understand why some diseases progress while others remain latent. In this view, “fitness” at the cellular level is defined by a clone’s ability to survive and multiply, but this does not always translate to the health of the entire person. A mutation that allows a cell to survive chronic inflammation might also make that cell prone to future dysfunction. This nuance requires a sophisticated approach to drug development, where the goal is to promote “good” clones while inhibiting those that might eventually lead to malignancy.
The environment plays a critical role in this selective process. Chronic stressors, such as pollution or persistent internal inflammation, act as “filters” that decide which cell lineages will thrive. For example, evidence suggests that lung inflammation caused by external pollutants can promote the expansion of preexisting KRAS mutations long before any tumor is visible. Understanding these environmental pressures allows researchers to intervene earlier, potentially redirecting the evolutionary path of a tissue before it reaches a tipping point toward overt disease.
Challenges in Interpretation: The Dual Nature of Clones
One of the most complex areas of current research involves Clonal Hematopoiesis of Indeterminate Potential, or CHIP. These are somatic mutations in blood cells that become more common as people age. While CHIP is often linked to a higher risk of cardiovascular disease, thought leaders have noted that its impact is highly context-dependent. In some clinical scenarios, such as bone marrow transplants or certain immunotherapies, these clones might actually improve patient outcomes or enhance the immune system’s ability to fight a tumor.
This duality presents a significant challenge for drug discovery. A target that appears beneficial in one tissue might be detrimental in another. Industry experts emphasize that the next phase of precision medicine will require a multi-organ, life-stage-specific understanding of somatic evolution. The complexity of these interactions means that “one-size-fits-all” inhibitors are likely to be replaced by more nuanced modulators that account for the unique clonal landscape of the individual patient.
The Future of Drug Discovery: A Somatic-First Framework
A Systematic Discovery Engine: The New Standard
A new standard for nominating therapeutic targets is emerging, structured around a systematic four-step discovery engine. This process begins with the precise selection of cells from diseased versus healthy tissues, followed by deep sequencing to identify every somatic variation. By analyzing the patterns of which clones “win” the evolutionary race within a diseased organ, researchers can nominate genes that are clearly under high selective pressure. This method provides a direct look at the genes that actually matter for cell survival in a real-world disease environment.
Validation of these targets involves checking whether mimicking or inhibiting these mutations can stop disease progression in experimental models. This framework is more direct than traditional methods because it relies on “experiments” already performed by nature within the human body. Instead of guessing which pathways might be relevant, scientists are simply reading the results of the evolutionary competition that has already taken place in the patient.
Potential Developments: Revertant Mosaicism and Beyond
Future developments are expected to lean heavily on the concept of “revertant mosaicism,” a phenomenon where a second somatic mutation naturally “fixes” an inherited genetic defect. These rare events provide a biological roadmap for gene editing. If nature can find a way to bypass a genetic error through a specific somatic change, scientists can use CRISPR and other editing tools to replicate that “bypass surgery” at the molecular level for all affected cells in a patient.
However, this somatic-first approach is not without risks. The dual nature of evolution means that a mutation providing resilience against one disease could theoretically increase the risk of another, such as cancer. The future of the field will depend on the ability to balance these outcomes. The goal is to develop “protective mimetics”—drugs that capture the benefits of somatic evolution without the long-term risks of uncontrolled cellular growth.
Conclusion: Navigating the Mosaic Future
The transition toward somatic genomics represented a fundamental shift in the understanding of human biology, moving the focus from a fixed genetic blueprint to a dynamic, evolving system. Researchers successfully demonstrated that the mutations acquired throughout a lifetime are not merely markers of decay but are often active participants in both the progression of disease and the maintenance of tissue health. By mapping these internal evolutionary struggles, the scientific community unlocked a repository of therapeutic targets that were previously invisible to traditional germline studies.
Stakeholders in the pharmaceutical and biotechnological sectors moved to integrate somatic profiling into the earliest stages of drug discovery. This integration allowed for the identification of treatments for idiopathic conditions that had long defied conventional medicine. The ability to distinguish between harmful clonal expansions and those that offered natural protection became a cornerstone of personalized therapeutic strategies.
Looking forward, the integration of these insights into routine clinical diagnostics will be essential. Researchers and clinicians must continue to refine the tools used to monitor the body’s internal mosaicism, ensuring that the benefits of cellular resilience can be safely translated into standard care. As the industry moves deeper into this “somatic-first” era, the focus remained on harnessing the power of natural selection to create a more responsive and life-stage-specific model of medicine.